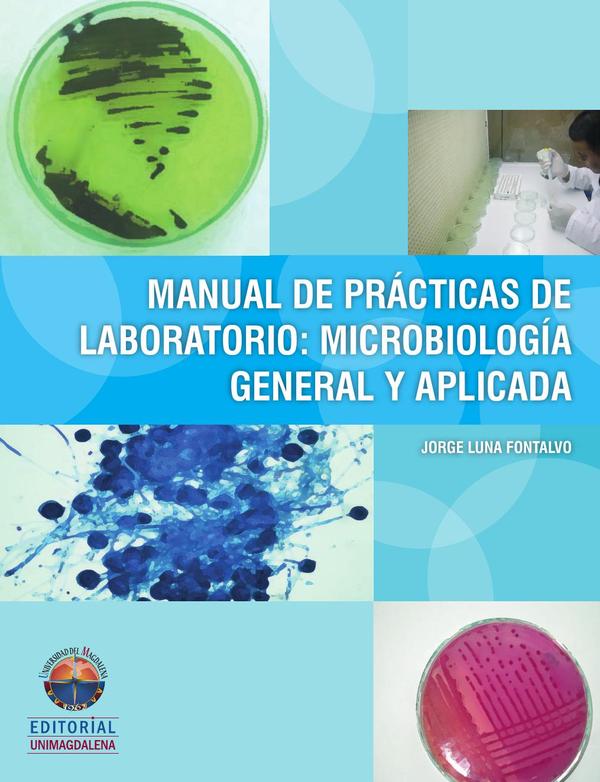

La Microbiología es una ciencia que se encarga de estudiar a los organismos vivos como hongos, bacterias y virus; incluyendo su morfología, fisiología, genética y ecología. El estudio de los microorganismos ha brindado en los últimos años grandes aportaciones para la solución de problemas biológicos básicos. Su fácil manejo, el crecimiento rápido, la gran capacidad adaptativa y otras características han hecho de los microorganismos el objeto de estudio preferido de la Bioquímica y la Genética. El presente texto tiene como propósito servir de guía al estudiante para el desarrollo del curso de Microbiología general. A través de las prácticas propuestas se espera que el estudiante compruebe los postulados teóricos de la Microbiología, como también los procedimientos de técnicas tintoriales y analíticas para la determinación de microorganismos indicadores de contaminación en muestras problemas (agua, suelo y alimentos). Al final de cada práctica se formulan una serie de preguntas, que el estudiante deberá resolver con el ánimo de ampliar los conocimientos correspondientes al tema tratado.El presente texto tiene como propósito servir de guía al estudiante para el desarrollo del curso de Microbiología general. A través de las prácticas propuestas se espera que el estudiante compruebe los postulados teóricos de la Microbiología, como también los procedimientos de técnicas tintoriales y analíticas para la determinación de microorganismos indicadores de contaminación en muestras problemas (agua, suelo y alimentos). Al final de cada práctica se formulan una serie de preguntas, que el estudiante deberá resolver con el ánimo de ampliar los conocimientos correspondientes al tema tratado.
Manual de prácticas de laboratorio: microbiología general y aplicada
$111,250
Disponibilidad:100 disponibles
SKU: PAP01100308Categorías: Biologia, ciencias de la vida, IMPRESOS A DEMANDA, MatemÁticas y cienciaEtiquetas: 9789587460452, Jorge Luna Fontalvo
| Peso | 0.303 kg |
|---|---|
| Dimensiones | 0.649 × 21.5 × 28 cm |
| ISBN | 9789587460452 |
| Autor | Jorge Luna Fontalvo |
| Editorial | UNIVERSIDAD DEL MAGDALENA |
| Año De Edición | 2012-05-15 |
| Número De Páginas | 112 |
| Idioma | |
| País | Colombia |
| Formato | Libro Impreso Bajo Demanda |
| Terminado | Tapa Blanda |
Sé el primero en valorar “Manual de prácticas de laboratorio: microbiología general y aplicada” Cancelar la respuesta

Valoraciones
No hay valoraciones aún.